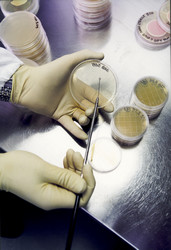

Accomplir l'efficacité et la précision dans les évaluations des risques pour les aliments GM
Des chercheurs financés au titre du projet GRACE ont récemment effectué un essai alimentaire de 90 jours sur des rats afin d'évaluer la sûreté de deux variétés différentes du maïs MON810 génétiquement modifié (GM). Lors de l'essai, des groupes de contrôle ont reçu une variété apparentée non-GM ou une des quatre variétés conventionnelles de maïs dans le cadre de leur régime alimentaire. Les résultats ont montré que les deux variétés de maïs GM testées n'enclenchaient aucun effet négatif sur les cobayes. L'objectif de l'étude était non seulement d'évaluer la sécurité des aliments GM, mais aussi l'efficacité et la précision de l'essai sur 90 jours. Les conclusions concernant la valeur du potentiel scientifique de ces essais (dans le but de mener des évaluations des risques sur les aliments GM) seront tirées une fois l'étude d'alimentation sur un an achevée, soit à la fin du projet en 2015. Ces premiers résultats sont d'actualité brûlante. Le Comité de l'environnement du Parlement européen a récemment voté pour autoriser les États membres d'interdire les cultures GM sur leur propre sol, même si ces dernières ont été approuvées à l'échelle de l'UE. Les organismes génétiquement modifiés (OGM) sont des plantes et des animaux dont les traits génétiques n'ont pas été modifiés de façon artificielle. La législation de l'UE prévoit qu'aucun OGM ne peut être cultivé en UE sans avoir reçu l'autorisation préalable, suite à l'évaluation des risques qui implique des agences d'évaluation nationale et l'Autorité européenne de sécurité des aliments (EFSA). Seul un maïs GM (le MON 810 utilisé pour l'essai) est actuellement cultivé à des fins commerciales dans l'UE. Il y a eu des appels pour améliorer l'efficacité de la phase d'évaluation des risques, qui peut prendre des années. Toutefois, la question clé est si une méthode de test plus rapide (telle que l'essai d'alimentation sur 90 jours mené par les chercheurs GRACE) peut identifier avec fiabilité les impacts de la consommation de cultures GM sur la santé à moyen et long termes. C'est ce que le projet tente de découvrir. À cette fin, GRACE, qui a reçu 6 millions d'euros de financement européen, est à la quête de deux objectifs de recherche clés. Premièrement, il vise à réviser les preuves sur les impacts sur la santé, environnementaux et socio-économiques des cultures GM, tout en prenant en compte les dangers et bénéfices possibles. Ces révisions seront menées de façon systématique, transparente et inclusive, et les résultats seront rendus accessibles au public à travers une base de données à accès libre. Deuxièmement, GRACE met à l'essai divers types d'essais d'alimentation des animaux et des méthodes de solutions de remplacement in vitro (par exemple dans les tubes à essai) afin d'en déterminer ce qui est approprié ou non. La Commission européenne examine si les essais alimentaires sur 90 jours devraient être une méthode de test obligatoire pour l'évaluation des risques des denrées alimentaires et des aliments pour animaux GM. Par conséquent, la récente étude de projet GRACE fournira des informations scientifiques précieuses pour aider la Commission à tirer une conclusion. Le projet se déroule de juillet 2012 à novembre 2015, et implique quelques 18 institutions de recherche provenant de 13 pays. Pour plus d'informations, veuillez consulter: GRACE http://www.grace-fp7.eu/(s’ouvre dans une nouvelle fenêtre)
Pays
Allemagne